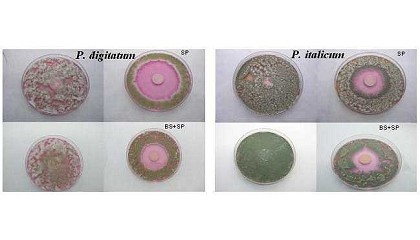

Resultados de la búsqueda "ctp"
Kodak reúne a sus distribuidores del Sur y Este de Europa en su planta de Osterode - 15/11/2016

ctp térmico, o el desarrollo de soluciones que permiten una producción más rápida y de mejor calidad de sensores para paneles táctiles con la impresión Micro 3D. Con centros de producción
Últimos avances en recubrimientos comestibles antimicrobianos para fruta entera - 07/09/2015
CTP). Instituto Valenciano de Investigaciones Agrarias (IVIA) - Fundación Agroalimed El creciente interés de los consumidores por productos naturales, más sanos, seguros y respetuosos con el medio ambiente ha hecho que en los últimos
Envol Graphic exhibe en Graphispag 2015 su nuevo sistema directo a plancha de pequeño y medio formato - 27/02/2015

CTP-E System. Redacción Interempresas CTP-E System. CTP-E System es un sistema directo a plancha con base inkjet sobre planchas de aluminio CTP-E Plates. Totalmente ecológico y de bajo
Grupo Fayat lanza en Bauma 2016 más de 25 novedades - 29/04/2016

CTP (costo total de propiedad) más bajo y su precio de compra competitivo, además de costos mínimos de transporte, montaje y mantenimiento. Bomag también ha hecho significativos avances a la hora
El Congreso de Directores de Seguridad celebra su sexta edición con gran éxito - 17/11/2016

CTP (coste total de propiedad) es la manera de cuantificar los costes asociados a un sistema de videovigilancia a lo largo de su ciclo de vida. En Axis trabajamos para
Fernando Gil, una imprenta con 70 años de historia - 23/12/2015

CTP con Prinect Image Control. ¿Calidad o cantidad? En esta área geoeconómica se ha dado un alto grado de concentración de empresas enfocadas a la construcción y, por tanto, aquí
La planta solar de Alcolea del Río, protagonista de Genera 2016 de la mano de Aros Solar Technology - 24/06/2016

CTP (Coste Total de Propiedad) de las centrales solares de media/alta potencia. El nuevo inversor se diferencia del anterior en que suma 300 kilovatios a los 500 que ya tenía
La prevención como forma de ahorro en el mantenimiento - 21/07/2014

CTP). Cervisimag Suele asociarse prevención a la salud o a los riesgos laborales, siempre cuando hablamos de personas. Pero, igual que nos debemos hacer chequeos para comprobar el estado de nuestra
Las soluciones de Esko son el pilar de un vasto ecosistema de impresión de envases - 01/06/2016
CtP Esko CDI son algunos de los componentes fundamentales de esta solución fácil de implantar. BST Eltromat (hall 10, stand D41 y hall 7, stand B22) ofrece una variedad amplia
Buenas prácticas en el uso de maquinaria que afectan a su funcionamiento - 14/07/2014

CTP) enfocándose en el uso que se hace de la máquina. Cervisimag Entre la documentación que acompaña la compra de cualquier equipamiento, hay uno al que no siempre se le presta
Hanwha Techwin, en colaboración con Veracity, ofrece la solución de red más segura y de mayor eficiencia energética - 08/04/2016

total de la propiedad (CTP)". La colaboración global se formalizó en una ceremonia en las oficinas centrales de Veracity en Reino Unido, en Prestwick, Escocia, el 6 de abril de 2016.
Transferencia de datos más segura en las aplicaciones móviles de la Industria 4.0 - 24/07/2015

CTP, se ajusta al estándar Desina y puede aplicarse en sala blanca. Gracias a su laboratorio interno, el más grande del sector con 1.750 m 2 de superficie, Igus puede
Diez factores para elegir la maquinaria que una empresa necesita - 30/06/2014

CTP) y las claves para reducir los costes y aumentar los beneficios relacionados con la compra de maquinaria. En ellos tiene en cuenta diferentes aspectos como los factores claves para
Delezenne Imprimeur adquiere una cosedora embuchadora Hohner HSB 8.000 - 30/06/2015

CTP sin químicos y obtiene a lo largo de los años 2009 y 2010 las certificaciones PEFC y FSC. Vista general de la HSB 8.000. Delezenne Imprimeur es en la actualidad
Litografía Rosés: El H-UV será la tecnología del futuro en offset - 08/03/2016

CTP, rotativas de color, marketing directo, máquina de plano, impresión digital, encuadernación en grapa y rústica, servicios auxiliares gracias al cual Litografía Rosés puede realizar cualquier producto impreso respondiendo a la necesidades
Redefiniendo el CtP de gran formato - 01/04/2013

CtP de gran formato - 01/04/2013: Basysprint introduce importantes novedades en este mercado Redefiniendo el CtP de gran formato La impresión en gran formato se encuentra en plena expansión. Rotativas con bobinas
Talleres Gráficos Soler instala el primer descargador Baumann de formato 8 en España - 07/09/2015

CTP (Computer to Plate), el revolucionario sistema electrónico de filmación de planchas que permite pasar directamente del PDF de la pantalla del ordenador a la plancha. Desde 2003 la empresa
Flujos de trabajo de producción potentes y flexibles para todas las tecnologías de impresión - 13/07/2015

CTP integradas con software, servicios, know-how y conexiones con terceros abarcan la más amplia gama de aplicaciones de impresión flexográfica digital. Para la impresión de alta calidad son necesarias
Kodak añade nuevas características a su CTP Magnus 800 - 05/07/2012

CTP Magnus 800 - 05/07/2012: Kodak añade nuevas características a su CTP Magnus 800 5 de julio de 2012 Nuevo sistema CTP Magnus 800. La nueva versión del CTP Kodak Magnus
Kodak pone en marcha una campaña de renovación de equipos CTPs con ahorros de hasta 20.000 euros - 12/04/2013

CTP Kodak entregando su viejo equipo CTP. Con este cambio dispondrán de soluciones de exposición térmica equipadas con tecnología SQUARESpot capaz de garantizar estabilidad, repetitividad, y precisión de reproducción hasta
